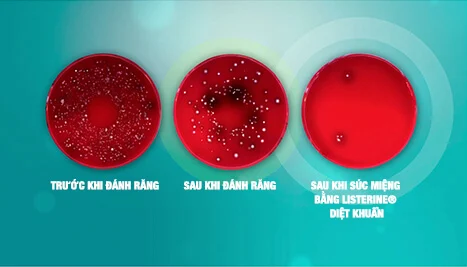

Có bao giờ bạn tự hỏi nhãn hiệu LISTERINE® ra đời như thế nào? Bác sĩ Joseph Lawrence, nhà sáng chế nước súc miệng LISTERINE® muốn phát minh của mình mang tên nhà khoa học đã có công mở đường khai phá. Bác sĩ phẫu thuật người Anh Joseph Lister là người đầu tiên tiến hành phẫu thuật trong phòng vô trùng với bột diệt khuẩn. Kết quả? Số lượng bệnh nhân được cứu sống gia tăng rõ rệt. Lấy cảm hứng từ đây, bác sĩ Lawrence đã tự chế tạo công thức độc đáo, lý tưởng để diệt khuẩn trong tế bào mô, như trong khoang miệng.
Từ phương pháp diệt khuẩn trong phẫu thuật đến nước súc miệng hiện đại

1860
Bác sĩ người Anh Joseph Lister đã lấy cảm hứng từ học thuyết của Louis Pasteur rằng vi khuẩn mà mắt thường không nhìn thấy chính là thủ phạm của nhiều loại viêm nhiễm.
1865
Bác sĩ Joseph Lister là người đầu tiên tiến hành phẫu thuật trong phòng vô trùng bằng cách phun bột diệt khuẩn vào không khí. Nhờ đó tỷ lệ tử vong được giảm hẳn.
1876
Bác sĩ Lister công bố thành quả của hai nhân vật có công hiện đại hóa hoạt động phẫu thuật: Bác sĩ Joseph Lawrence và Robert Wood Johnson, nhà sáng lập Johnson & Johnson.
1879
Với cảm hứng từ bác sĩ Lister, Lawrence sáng chế nước súc miệng LISTERINE®, một sản phẩm diệt khuẩn độc đáo dùng trong phẫu thuật và rửa vết thương.
1881
Công ty Dược phẩm Lambert Pharmaceutical Co. mua bản quyền công thức LISTERINE® và bắt đầu sản xuất, tiếp thị sản phẩm.
1895
Nghiên cứu cho thấy nước súc miệng LISTERINE® có hiệu quả diệt khuẩn trong khoang miệng và được giới nha sĩ quan tâm.
1914
Nước súc miệng LISTERINE® trở thành sản phẩm kê toa đầu tiên tại Hoa Kỳ để được bán rộng rãi và tiếp thị như là sản phẩm diệt khuẩn đường miệng.
1920
Nước súc miệng LISTERINE® cho ra đời thuật ngữ "hơi thở có mùi" cho tình trạng hôi miệng và doanh số tăng vọt.
1997
Nước súc miệng LISTERINE® giới thiệu phim quảng cáo đầy ấn tượng, đến "tiên răng" cũng đành "thất nghiệp".
2006
Nước súc miệng LISTERINE® đưa ra một tuyên bố táo bạo: súc miệng bằng LISTERINE® giúp giảm mảng bám đến 56% so sới chải răng đơn thuần.
2008
LISTERINE® SMART và LISTERINE® HEALTHY WHITE™ VIBRANT ra mắt tại thị trường Hoa Kỳ.
2009 - 2011
LISTERINE® giới thiệu dòng sản phẩm TOTAL CARE tại thị trường Hoa Kỳ.
2012
LISTERINE® giới thiệu dòng sản phẩm ULTRACLEAN® thay thế cho dòng nước súc miệng ADVANCED.
2012
LISTERINE® giới thiệu Fluoride Defense thay thế cho LISTERINE® RESTORING.
2014
LISTERINE® ra mắt dòng chỉ nha khoa tự nhiên NATURALS tại thị trường Hoa Kỳ.